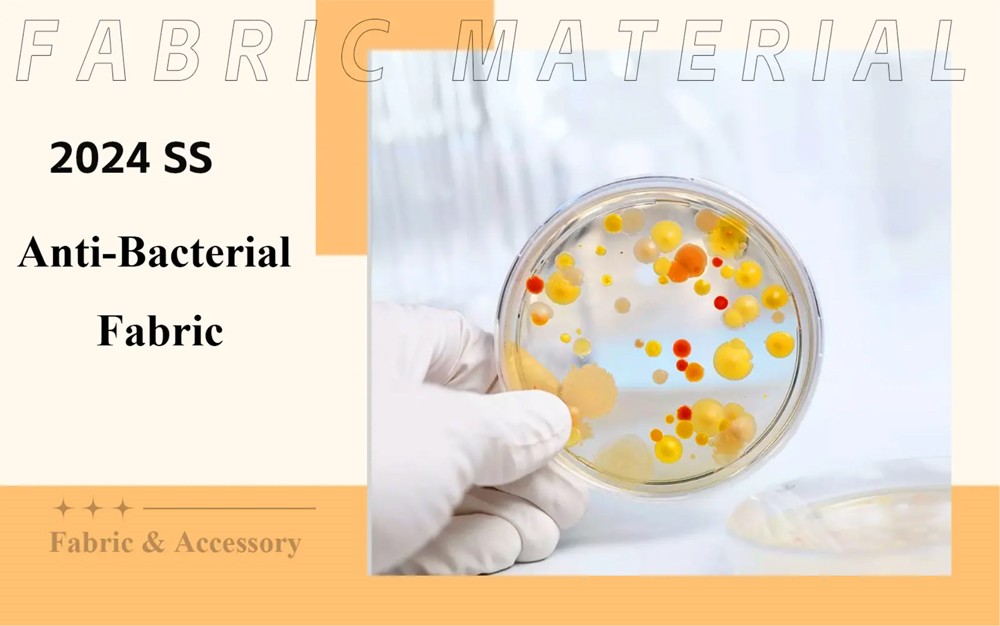
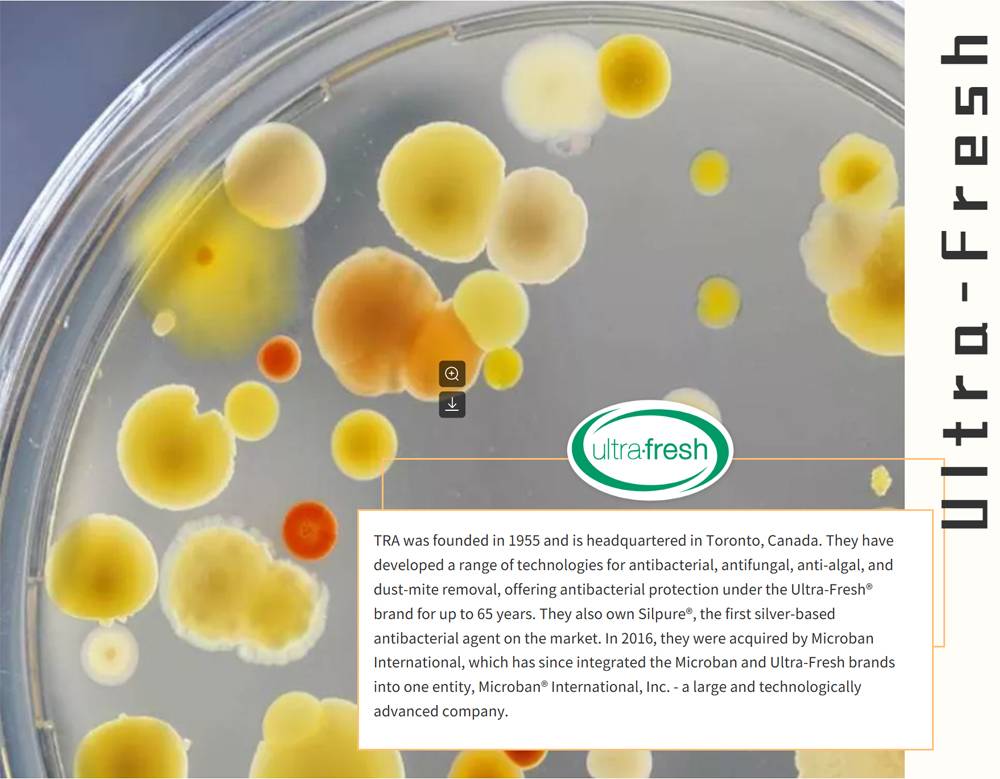

With an increasing focus on health, people are demanding higher standards of hygiene, cleanliness, and disinfection.As a manufacturer of Leggings Wholesale, we have already started to pay attention to it in 2018 and regard it as a key development object of product parameters. Antimicrobial performance refers to a product's ability to resist bacteria, viruses, and other microorganisms. In the post-pandemic era, consumers are more concerned about the hygiene and safety of the items they use, hoping to reduce the harm caused by microorganisms to the human body through antimicrobial performance. Therefore, products with strong antimicrobial capabilities will become the new favorite in the market, attracting more consumers to purchase and use them. This report highlights the three most popular antimicrobial technology brands in the market, explaining their technical points and providing commercial application cases for reference.


1.Technical Points
The main mechanism behind Ionic+ technology in Ionic+ is the release of silver ions from yarns, fibers, and fabrics. When Ionic+ technology is incorporated into a product, the ions released in the presence of moisture (such as natural skin-moisture vapor) help counteract negatively charged ions. This action helps suppress and eliminate microorganisms on the product surface, protecting it from microbial influences. Ionic+ minerals can be used for treatment in all three ways: metallization, extrusion, and surface treatment.
2.Advantages
1. High-purity silver antibacterial technology.
2. The self-cleaning, continuous, and sustained release of silver ions without shedding elemental silver.
3. Fighting against microorganisms that accumulate on fabrics.
4. Eliminating bacteria that cause odors on fabrics.
5. Reducing the frequency of washing, conserving energy, water, and natural resources.
6. Reducing the degradation of fabrics over time.
7. Permanent protection, metalization, and extrusion processing extend the product's lifespan (over 200 washes).
3. Standards
1. EPA registered
2. Compliant with BPR standard
3. OEKO-TEX Standard 100 certified


Men's underwear brand MACK WELDON, based in New York, has partnered with NOBLE BIOMATERIALS to develop the "SLIVER" line of intimate products using their IONIC+® antimicrobial technology combined with Supima® cotton or Tencel fibers, satisfying the needs for both active and casual wear.
Using the patented Silver-plated Ionic+ Fabric technology, INNOTIER has developed a range of sustainable lifestyle clothing. From everyday wear to sportswear, all products are capable of suppressing and eliminating 99% of viruses and bacteria within 30 seconds, making us the first brand in the world to use this technology.
The women's athletic brand Athleta utilizes IONIC+® antibacterial technology to develop stylish and functional athletic leisurewear, as well as underwear and other categories.

Silpure® Highlights
Silpure is the first commercially viable textile processing method that utilizes advanced and validated antimicrobial properties of silver. This unique patented technology contains ultra-fine silver crystals that can only release silver ions at a controlled rate when conditions for bacterial growth are present. By carefully controlling the size and shape of the particles during production, Silpure avoids potential fabric discoloration that may occur with other silver antimicrobial fabric treatment options.
Ultra-Fresh® Highlights
By inhibiting the growth of bacteria, molds, and fungi, the lifespan of the product can be extended. It can be applied to most stages of the manufacturing process - yarns, fabrics, and even finished products themselves. Certain ultra-fresh treatments can even be added during the extrusion process of synthetic textile fibers, providing long-lasting built-in protection.
Advantages
Silpure®
1. Advanced antimicrobial protection uses advanced silver technology to protect fabric from bacteria, mold, mildew, and fungi.
2. Lasting freshness eliminates odors by controlling bacteria that can cause problems.
3. Permanent and washable textiles provide long-lasting bacteria control, even on elastic fabrics such as polyester.
4. Safe and compatible with other technologies.
Ultra-Fresh®
1. Reliable antimicrobial protection protects fabric by limiting the growth of bacteria, mold, mildew, and fungi.
2. Provides excellent durability, even after multiple washings or dry cleanings.
3. Applied during manufacturing and designed for use with other textile additives, such as softeners and flame retardants, to provide flexibility and be compatible with other technologies.
Standards
1. Oeko-Tex certified
2. Registered with EPA
3. Compliant with BPR standards


Van Heusen launches a 16-hour comfortable bra collection designed specifically for women on the go. All products utilize Ultra-Fresh® technology to preserve freshness and provide a refreshing and comfortable experience.
American classic menswear brand Brooks Brothers, which has been around for more than two centuries, is incorporating ultra-fresh antibacterial technology into its men's undershirt and underwear collection. This helps prevent harmful odors caused by bacteria from developing in the materials.
The American handmade knitting brand St. Croix uses yarns treated with Silpure to produce products, including pullovers, polo shirts, crewneck sweaters, and T-shirts, which are all treated to achieve a lasting freshness.


SilverShield®
The SilverShield® technology of MyCoShield™ innovatively combines the natural antibacterial properties of silver in the form of silver chloride with a unique carrier system, thereby improving the durability and service life of silver antibacterial agents. This combination produces a highly washable and abrasion-resistant surface. SilverShield® interrupts bacterial metabolic processes and inhibits microbial reproduction to prevent the growth of microorganisms on clothing and other fabrics. MyCoShield™'s unique carrier system allows silver chloride to penetrate into the fabric to provide long-lasting odor control and antibacterial protection. SilverShield® is integrated during the finishing process to provide easy and effective antibacterial protection for textiles.
ZPTech®
ZPTech® is a range of multifunctional pyrithione zinc products designed for various product applications. The ZPTech® zinc-based antimicrobial solution is provided to customers in liquid form, directly incorporating the antibacterial capability of zinc into textile fibers and foam, making them long-lasting and effective. ZPTech® technology is available in both aqueous and non-aqueous carriers; non-aqueous carriers are particularly suitable for foam manufacturing processes with strict moisture control requirements.
Advantages
SilverShield®
1. Reduces 99% of intestinal microbiota within 2 hours at room temperature, far exceeding other competing products.
2. Silver ion active ingredients can remain on the product surface for a long time and release continuously 24/7.
3. The antibacterial function is not affected even if the product is scratched after processing.
ZPTech®
1. Strengthens and protects products used in humid environments.
2. Proven to effectively combat 99.9% of bacteria, fungi, algae, and other microorganisms.
3. Heat-stable and suitable for various manufacturing processes and products used in humid environments.
4. Can be safely encapsulated in a custom carrier without affecting the function and appearance of the product.
Standards
1. ISO 9001:2015
2. bluesign
3. OEKO-TEX


Li-Ning® has recently released a new line of tight and shaping pants (Innolock). Li-Ning has teamed up with industry leader in antibacterial protection and odor control, SilverShield® , using cutting-edge antibacterial and odor control technology to help the products achieve optimal performance.
Reebok has partnered with Microban to ensure that its athletic apparel is protected from stains and bacteria that cause odors. Microban's antimicrobial technology is infused into Reebok's authentic NFL replica jerseys during the manufacturing process, and also used in their 7-inch training shorts for women.
After understanding consumers' demands for apparel performance and sustainability, Danskin® and SilverShield® have partnered closely to create a series of clothing that provides lasting freshness and other values for consumers.


If you need a leggings wholesale now or in the future, please contact us.
